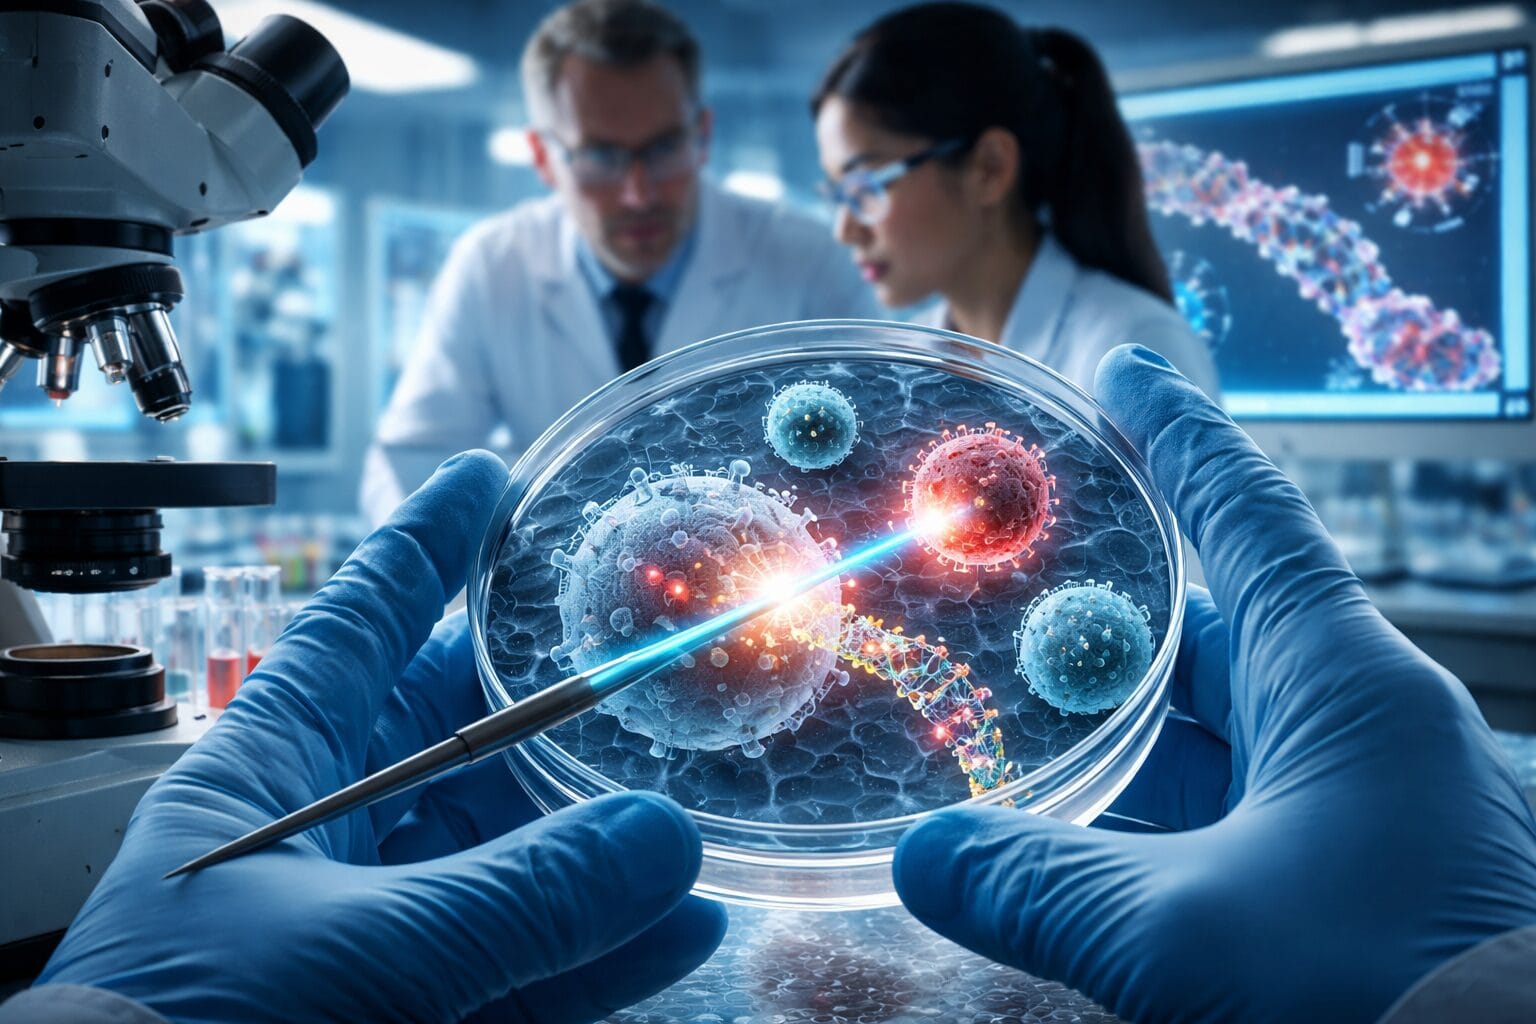
Did scientist just remove HIV from human immune cells using Crispr?

💥 HIV ko Science ne remove Kar Diya — here is the real business behind it!
Doctors aur scientists ne T-cells (wo immune cells jo HIV target karta hai) ke andar se HIV ka genetic code (DNA) ko CRISPR jaisi gene-editing technology se remove kar diya he.
👉 Matlab lab petri dish me virus remove ho gaya aur cells phir se healthy dikh rahe the — yeh ek scientific milestone hai.
But hold on — abhi bhi yeh sirf experiments me hua hai, human patients pe fully proven cure nahi hai.
see this video :
📈 Why This is a Big Revolution in Medical-Tech 🌍
Chalo isko ek average business guy ke angle se samajhte hain — simple aur seedha.
also read : Seedance 2.0 — will change Film Industry Forever! but Kaise?
🧬 1. Superseding the Old Model – Game Change Hai Boss
Old HIV treatment = ART (Antiretroviral Therapy)
Matlab virus ko control karo, khatam nahi.
New gene-editing tech jaise CRISPR = virus ko DNA level pe nikaal do.
Yeh literally “Patna se rocket launch” level ka jump hai. 🚀
ART kya karta hai?
✔ Virus ko suppress karta hai
❌ Lekin HIV body ke cells me chup jaata hai aur wapas aa sakta hai
CRISPR approach kya try karta hai?
👉 HIV ka DNA jo cells me chipka hota hai, usko directly cut-out karna.
Management se cure tak ka shift — that’s fundamentally different business model.
💰 2. Market Potential – millions nahi, Billions wali soch
Agar gene editing HIV ko manage nahi, balki cure kar de:
✅ Lifetime drugs khatam
✅ Roz ki pills khatam
✅ Regular hospital visits kam
✅ Long-term dependency model break
Abhi ka pharma model subscription jaisa hai — lifelong revenue.
Lekin ek “once-and-done” cure?
That’s premium, high-ticket, breakthrough therapy.
Duniya me approx 38–40 million log HIV ke saath jee rahe hain.
Agar even ek portion ko cure mil gaya, global healthcare economics hil sakti hai.
VCs aur investors ke liye?
Yeh woh type ka product hai jisme “next Apple/Facebook moment” dikh sakta hai biotech me. 📈
also read : How meta wants to builds monopoly in AI competition!
⚙️ 3. Tech Spillover – Real Power Yahan Hai
CRISPR sirf HIV tak limited nahi hai.
Imagine karo:
- Cancer ke specific mutations edit karna
- Genetic diseases ko birth se pehle correct karna
- Immune disorders ko tweak karna
Ek hi platform technology jo multiple diseases ko target kare.
Yeh candle se electricity wale jump jaisa hai. 🔌
Platform tech = exponential growth potential.
💼 Business Strategic Moves – Smart Money Kahan Ja Raha Hai?
👉 Companies like Excision BioTherapeutics already CRISPR-based HIV therapy develop kar rahi hain (example: EBT-101).
Unko regulatory fast-track bhi mila hai — matlab authorities bhi serious hain.
👉 Big Pharma quietly CRISPR startups ko closely watch kar rahi hai.
Kyun?
Acquisition ya early investment ka mauka miss nahi karna chahte.
👉 Policy shift bhi aa sakta hai.
Agar HIV cure possible ho gaya:
- Insurance models change honge
- Government healthcare budgets re-allocate honge
- Drug reimbursement systems rethink honge
Yeh sirf medical innovation nahi — yeh economic restructuring ho sakta hai.
🧠 Final Business Mindset Takeaway
HIV cure via gene editing:
Old Model: Control & Cashflow
New Model: Cure & High-Valuation Breakthrough
Yeh healthcare ka Netflix moment ho sakta hai — DVD rental model khatam, streaming shuru.
Medical revolution + Financial revolution = Rare combo.
Aur jab science + scalable platform tech + massive global market ek saath milte hain…
tab disruption guaranteed hota hai. 🚀
🚧 Reality Check — Why It’s Not a Cure Yet

Now let’s be honest — business men love numbers and timelines:
⏱️ Lab result ≠ real cure yet. These edits were done in a controlled lab environment — not in live patients yet.
🔬 Human bodies are way more complex than petri dishes. Gene delivery, safety, unintended edits — everything must be tested in big clinical trials.
💊 A similar gene editing therapy in early human trials (like EBT-101) showed safety but didn’t hold virus suppression on its own at first tested dose.
🧠 :
*“Dosto, imagine aapne ek product banaya jisse duniya ke sabse badi medical problem ka root cause hi nikal jaata hai. Filhaal lab level pe scientists ne ye *CRISPR tool se HIV ko cells se delete kar diya hai — matlab virus ab cells ke DNA me nahi bacha. Agar ye successful ho gaya full human level pe… bhai, yeh HIV ka pura danda hi tut jayega! Aur iske saath multi-billion dollar industry ka generation hoga — pharma companies, biotech startups, gene therapy clinics sab bohot jyada profit karenge. Lekin abhi hum stage 1 pe hain — prototype bana hai, testing chal rahi hai.”
🔥 Final Takeaway
✔ Yes — CRISPR has shown HIV removal from human cells in lab tests.
✔ That’s a major scientific revolution with huge business and medical implications.
✔ Full cure in humans still requires years of trials and regulatory approvals.
✔ If it works — it can change disease treatment economics forever.
also enjoy :